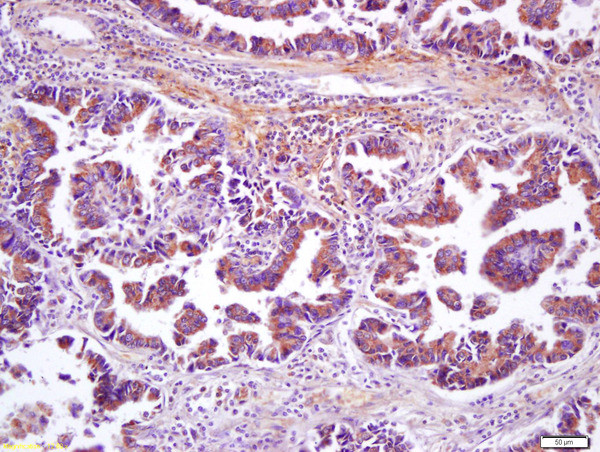
Wnt8b Antibody in Immunohistochemistry (Paraffin) (IHC (P))

Search
Bioss
Wnt8b Polyclonal Antibody
{{$productOrderCtrl.translations['antibody.pdp.commerceCard.promotion.promotions']}}
{{$productOrderCtrl.translations['antibody.pdp.commerceCard.promotion.viewpromo']}}
{{$productOrderCtrl.translations['antibody.pdp.commerceCard.promotion.promocode']}}: {{promo.promoCode}} {{promo.promoTitle}} {{promo.promoDescription}}. {{$productOrderCtrl.translations['antibody.pdp.commerceCard.promotion.learnmore']}}
产品信息
BS-6245R
种属反应
宿主/亚型
分类
类型
抗原
偶联物
形式
浓度
规格
纯化类型
保存液
内含物
保存条件
运输条件
靶标信息
The WNT gene family consists of structurally related genes which encode secreted signaling proteins. These proteins have been implicated in oncogenesis and in several developmental processes, including regulation of cell fate and patterning during embryogenesis. This gene is a member of the WNT gene family. It encodes a protein which shows 95%, 86% and 71% amino acid identity to the mouse, zebrafish and Xenopus Wnt8B proteins, respectively. The expression patterns of the human and mouse genes appear identical and are restricted to the developing brain. The chromosomal location of this gene to 10q24 suggests it as a candidate gene for partial epilepsy.
仅用于科研。不用于诊断过程。未经明确授权不得转售。
篇参考文献 (0)
生物信息学
蛋白别名: epididymis secretory sperm binding protein; Protein Wnt-8b; wingless related MMTV integration site 8b; wingless-type MMTV integration site family, member 8B; WNT 8b
基因别名: WNT8B
UniProt ID: (Human) Q93098, (Mouse) Q9WUD6
Entrez Gene ID: (Human) 7479, (Mouse) 22423, (Rat) 293990